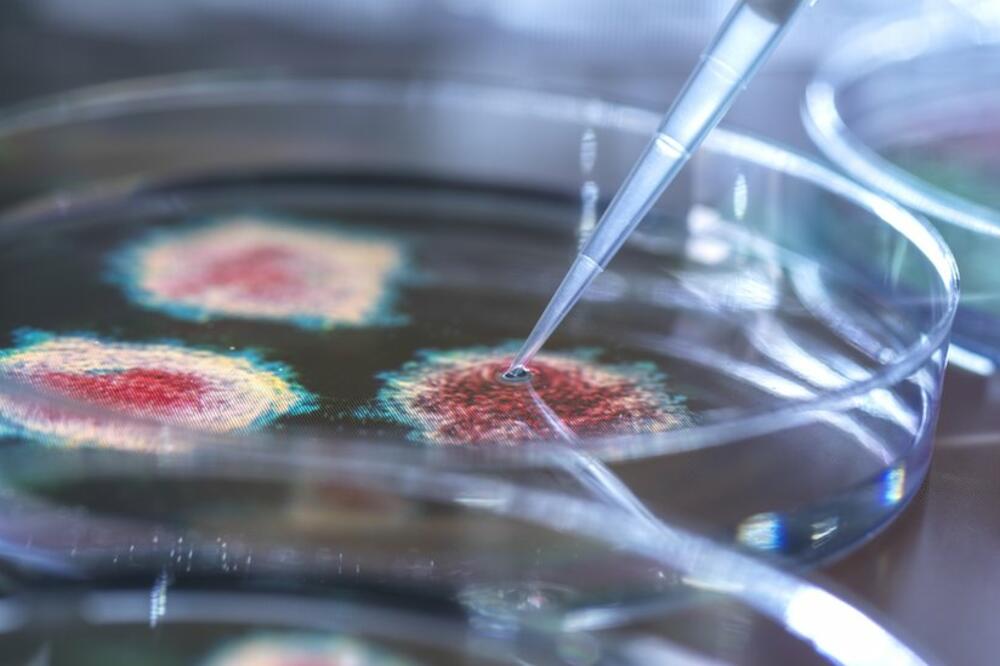
Foto: Getty Images

„Godinama me zanima alternativa medicina.
„A onda je ono što se desilo sa korona virusom podstaklo jedan sasvim novi nivo mog interesovanja", priča Veronika Haupt iz obalskog doma blizu Kejptauna u Južnoj Africi.
Ona nije želela da objavimo njenu fotografiju.
Naturopata je.
Nudi „prirodni" zdravstveni savet koji možda nije zasnovan na naučnim dokazima.
I njen put je dobro poznat.
- Od četa sa lekarima, do „zdravstvenog Bukinga": Kako je telemedicina stigla na Balkan
- Zašto pametni ljudi veruju u mitove o korona virusu
- Ivermektin i korona virus: Šta je istina
Viktorija se prvo zanimala za velnes i uživala u čitanju o nekonvencionalnim zdravstvenim lečenjima.
Potom je počela da sumnja u sastojke vakcina protiv kovida, pogotovo što su bile obavezne samo na nekim radnim mestima.
Ali se njen put tu razdvojio od mnogih iz te „velnes" zajednice.
„Mislim da je čitava ideja o zaraznim bolestima koje možete da dobijete od nekog drugog apsolutni mit koji se nameće čovečanstvu mnogo, mnogo decenija", kaže mi Veronika.
Ona, kao i sve veći broj ljudi na internetu, uprkos svim naučnim dokazima, ne veruje da bacili koji izazivaju bolesti uopšte postoje.
Analiza podataka sa društvenih mreža traženjem ključnih reči koje koriste negatori bacila pokazuje da ova rasprava jedva da se vodila pre 2020. godine i da je narasla sa početkom pandemije kovida.
I na tome se nije zaustavila.
Pogledajte i ovaj video
Nastavila je da raste, sa najviše pominjanja relevantnih ključnih reči 2023. godine, više nego bilo kad u prethodne tri godine na vrhuncu pandemije.
Grupe posvećene negiranju bacila imaju desetine hiljada članova na Fejsbuku i u aplikaciji za poruke na Telegramu.
Neki članovi veruju da virusi ne postoje, drugi da bacili postoje, ali da ne izazivaju bolesti.
Mnogi se pozivaju na opovrgnutu teoriju iz 19. veka.
I baš dok je teorija da bacili izazivaju bolesti u to vreme počela da se dokazuje, francuski naučnik po imenu Antoan Bešam pojavio se sa idejom zvanom teorija o terenu.
Prema njoj, bacili su bezazlena bića koja mutiraju u nešto što izaziva bolesti samo u nezdravom telu.
Bešamovu teoriju su otpisivali kako se pronalazilo sve više i više dokaza da bacili izazivaju bolesti, ali su se neke grupe na internetu baš sada uhvatile za njegovu ideju.
Čini se da to ima manje veze sa iznenadnom posvećenošću teoriji francuskog naučnika iz 19. veka, a više sa potpunim odbacivanjem bilo čega opšteprihvaćenog.
Ako vlada ili neka zdravstvena institucija kažu nešto, onda to mora da je automatski pogrešno, što nije isto kao dovođenje vlade u pitanje ili analiziranje već postojećih dokaza.
Doktor Den Vilson, molekularni biolog koji ima edukativni kanal na Jutjubu po imenu Debunk the Funk, kaže da se ova nenaučna verovanja uklapaju u širu predstavu o „velnesu".

To je pokušaj postizanja opšteg osećanja fizičkog i psihološkog blagostanja, preko ishrane, vežbanja i drugih zdravih praksa.
On često znači i odbacivanje farmaceutskih lekova, koji se doživljavaju kao „neprirodni" i izrodio je milione objava na društvenim mrežama.
Doktor Vilson kaže da velnes podržava objašnjenja bolesti koja pružaju pojedincu osećaj kontrole.
Samom promenom onoga što unosite u sebe, tvrdi ovaj pokret, vi možete ne samo da izbegnete bolest, već da živite najboljim mogućim životom.
„On ne mora da ide skroz do teorije o poricanju bacila.
„Ideja je da možete da uzimate suplemente na određeni način ili da živite određenim stilom života, a da ne morate da brinete o bolestima", kaže doktor Vilson.
Naravno, ne izazivaju sve bolesti bacili.
Njih može da izazove genetika, stil života ili naša životna sredina.
Ali Veronika veruje, bez ikakvih konkretnih dokaza, da sve bolesti izaziva nešto toksično što ulazi u naša tela kao što su zagađenje ili možda elektromagnetne frekvencije.
„Vaše zdravlje je u vašim rukama. Nije u rukama doktora", rečenica je koju često govori klijentima.
I tu negiranje bacila može da ima ozbiljne posledice.
- „Iscelitelj me je ubedio da sam HIV negativna“
- Da li studenti u Srbiji zaista ne žele da se vakcinišu
- Nadrilekarstvo u Srbiji i dalje nekažnjeno
Najveća grupa na Fejsbuku posvećena verovanju da bacili ne izazivaju bolesti vrvi od saveta i uputstava kako izbegavati lekare, medicinu i vakcine.
Ona je narasla sa 150 članova 2019. godine na današnjih više od 30.000.
„Teorija o negiranju bacila i anti-vakcinalne mase imaju mnoga preklapanja.
„Rekao bih da krug negatora teorije o bacilima postoji u okviru anti-vakcinalnog kruga", kaže doktor Vilson.
On je posmatrao kako se ovo pretvaralo iz nečega što je nekada viđao samo s vremena na vreme u nešto što je sve više glavno obeležje anti-vakcinalnih argumenata.
„Zovem ih nekom vrstom ravnozemljaša biologije, jer, slično ravnozemljašima, možemo da im pokažemo fotografije Zemlje kao lopte, ali će ljudi to i dalje negirati.
„Možemo da uzmemo virus i da zarazimo životinju njim, da je učinimo bolesnom, možemo da nađemo tu istu genetsku sekvencu u ljudima i pratimo je kroz populaciju dok se prebacuje sa osobe na osobu i da pratimo talas bolesti kako se širi populacijom", objašnjava.
- Zašto dolaskom Rusa raste popularnost homeopatije u Srbiji
- Da li se antibioticima uništavaju i neophodne bakterije u ljudskim crevima
- Vakcine protiv kovida: Tvrdnje u vezi sa plodnošću i pobačajem potpuno neutemeljene
Virusi i drugi bacili mogu da se vide pod mikroskopom, dodaje on.
„Ali uprkos obilju dokaza, različiti oblici negiranja teorije o bacilima uzimaju sve više maha.
„Na primer, ideja da HIV ne izaziva sidu - brinem se da to sve više postaje glavna teorija zavere."
Ranih 2000-ih, u Veronikinoj rodnoj Južnoj Africi, tadašnji predsednik Tabo Mbeki odbijao je da prihvati činjenicu da sidu izaziva virus HIV-a.
Nije želeo da obezbedi antiretroviralne lekove koji spasavaju živote sprečavanjem da se virus razmnožava u telu.

Procenjuje se da je ovaj stav izazvao više od 300.000 smrti koje su mogle da se spreče, pokazuju rezultati studije sa Univerziteta Harvard.
Ljudi koji rade na prevenciji HIV-a i lečenju na terenu u Južnoj Africi kažu mi da je situacija danas neprepoznatljiva u odnosu na onu od pre 20 godina i da negiranje side nije problem sa kojim moraju da izlaze na kraj.
Ali tihi ritam udaranja u doboš sumnje iz određenih krugova dovoljan je da istraživači HIV-a poput Roberta Pereire naćule uši.
„Mislim da to nije u redu, znate, naročito kad je tako nešto nanelo toliko bola u ovoj zemlji. Krv mi proključa od toga.
„Ne želite da vidite kako se istorija ponavlja, ali čini se da ima običaj da se prilično često ponovi", kaže on.
Pogledajte i ovu priču
Pratite nas na Fejsbuku,Tviteru i Vajberu. Ako imate predlog teme za nas, javite se na bbcnasrpskom@bbc.co.uk
Pogledajte još:
Preuzmi aplikaciju i prati vijesti
PRATITE NAS NA